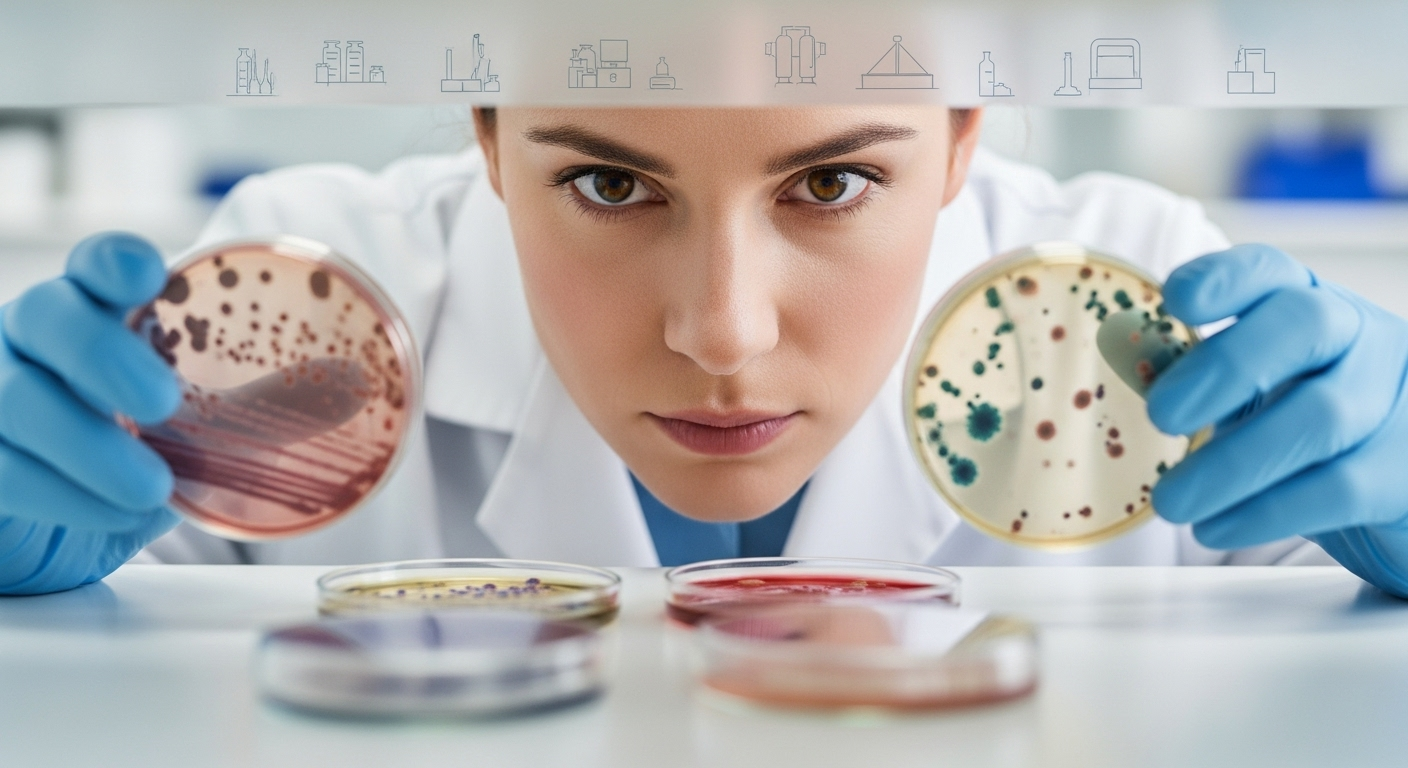
Transplantation fécale : une étude explore ses effets sur le diabète et les maladies cardiovasculaires

Transplantation fécale : une étude explore ses effets sur le diabète et les maladies cardiovasculaires
Auteur: Adam David
L’idée peut paraître déroutante, voire un peu scabreuse. Pourtant, une piste scientifique de plus en plus sérieuse suggère qu’une simple gélule, issue d’un don de microbiote fécal, pourrait être une arme redoutable contre le diabète et les maladies cardiaques. Une étude néo-zélandaise vient de confirmer ses effets bénéfiques… sur le très long terme.
Le mal silencieux du syndrome métabolique

Avant de plonger dans les détails de cette thérapie, un petit rappel s’impose. Le syndrome métabolique, ce n’est pas une maladie unique, mais plutôt un cocktail de problèmes de santé qui augmentent considérablement les risques de développer un diabète de type 2 ou une maladie cardiovasculaire. On parle ici d’un tour de taille qui s’élargit, d’une tension qui grimpe, d’un taux de sucre dans le sang qui s’emballe.
Ce déséquilibre est souvent la conséquence de notre mode de vie : alimentation trop riche, manque d’activité physique, stress chronique… C’est un mal sournois, qui s’installe sans faire de bruit, mais dont les conséquences peuvent être dévastatrices.
Une expérience audacieuse venue de Nouvelle-Zélande

Face à ce fléau de santé publique, des chercheurs de l’Université d’Auckland ont tenté une approche radicalement différente. Dès 2020, ils ont recruté 87 jeunes adultes en situation d’obésité. Leur hypothèse : et si l’on pouvait « réinitialiser » un métabolisme défaillant en lui greffant les bactéries intestinales d’un donneur sain ?
Concrètement, une partie des volontaires a reçu des gélules contenant ce fameux microbiote transplanté (FMT), tandis que l’autre recevait un simple placebo. L’objectif était de voir si cette nouvelle flore intestinale pouvait changer la donne.
Des résultats surprenants, quatre ans plus tard

La première surprise, c’est que le traitement n’a pas fait maigrir les participants. Du moins, pas de manière significative. Mais ce n’était pas l’essentiel. En réexaminant récemment 55 des participants, quatre ans après la prise unique des gélules, les scientifiques ont fait une découverte capitale : non seulement les bénéfices sur la santé métabolique persistaient, mais ils s’étaient même améliorés. On a notamment observé une réduction de la masse grasse corporelle.
Plus fou encore, l’analyse a montré que le microbiote greffé était toujours là, bien implanté et actif dans les intestins des receveurs, quatre ans après une seule administration. Un effet d’une longévité inattendue.
Une seule dose pour des années de protection ?

C’est cette durabilité qui enthousiasme particulièrement les médecins. « Ce qui est impressionnant, c’est qu’un seul traitement a produit une réduction spectaculaire du syndrome métabolique qui a duré au moins quatre ans », souligne l’endocrinologue pédiatrique Wayne Cutfield, l’un des auteurs de l’étude.
Il traduit lui-même les implications : « Cela signifie que les participants ont un risque beaucoup plus faible de développer un diabète et une maladie cardiaque à long terme. » En clair, une seule cure de gélules pourrait offrir des années de protection contre deux des plus grandes menaces pour notre santé.
Au-delà du métabolisme, un horizon bien plus large

Et les promesses de la transplantation fécale ne s’arrêtent visiblement pas là. D’autres travaux de recherche explorent son potentiel face à certains cancers, des maladies neurodégénératives ou même pour ralentir certains aspects du vieillissement. Et pour ceux que l’idée rebute encore, les chercheurs le rappellent : les gélules modernes sont conçues pour être totalement neutres, sans goût ni odeur, protégeant leur précieux contenu jusqu’à destination.
Vers une médecine personnalisée de nos entrailles

Bien sûr, le chemin est encore long avant de voir ces gélules dans nos pharmacies. Les chercheurs doivent maintenant mener des essais à plus grande échelle pour confirmer ces résultats spectaculaires. Le but ultime ? Isoler les quelques bactéries « super-héroïnes » responsables de ces bienfaits, pour peut-être, un jour, créer un probiotique ciblé et sur mesure. Une petite révolution médicale qui, littéralement, vient de nos entrailles.
Selon la source : science-et-vie.com










